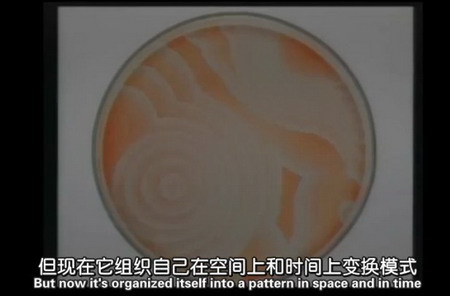

视频截图
学校:剑桥大学
讲师:多人
集数:8
字幕:中英双文
授课语言:英文
类型:科学
课程介绍
自1986年起,每年第二个学期,达尔文学院都会举办一个八节系列讲座。2012年的主题是“生命”,由该领域权威人物主讲,受众为普通大众。
学院介绍
剑桥大学位于英格兰的剑桥镇,是英国也是全世界最顶尖的大学之一。英国许多著名的科学家、作家、政治家都来自于这所大学。剑桥大学也是诞生最多诺贝尔奖得主的学府。剑桥大学和牛津大学齐名为英国的两所最优秀的大学,被合称为"Oxbridge"。

剑桥大学公开课:生命 > 从基因到生命的多样性(1-8集)
剑桥大学公开课:生命 > 从基因到生命的多样性(第1集)
http://v.163.com/movie/2012/10/D/I/M85KCL7B8_M85MB1JDI.html
分集介绍:剑桥系列讲座之《从基因到生命的多样性》,演讲者是来自牛津大学的生物学教授迈克尔·奥坎,他将从基因生物学的角度讲述,人类到底处于生命树上的哪个位置,与那些看起来毫不起眼的低等动物之间有什么千丝万缕的联系。如果基因如此相似的话,生命的多样性又从何而来?其实不同物种之间具有惊人的基因相似点,这些基因从共同的祖先继承并得到了完善的保存,而造成生命多样性的不仅是表达的基因,更重要的是指示系统编码蛋白质的上游基因,而这些基因之间的复杂的互动对生命多样性的产生起到了关键的作用。
剑桥大学公开课:生命 > 废墟中的生命(第2集)
http://v.163.com/movie/2012/10/L/5/M85KCL7B8_M85MB1ML5.html
分集介绍:这是达尔文学院关于生命主题系列讲座的第二堂课,演讲者是任教于剑桥伊曼纽尔学院的Robert Macfarlane。其演讲的主题是废墟中的生命,描述作家和艺术家怎样用文学和艺术来描写未来废墟。
剑桥大学公开课:生命 > 生命的火花(第3集)
http://v.163.com/movie/2012/10/Q/A/M85KCL7B8_M85MB1PQA.html
分集介绍:剑桥系列讲座之《生命的火花》,来自牛津大学的生物学家佛朗西斯?阿希克夫向我们讲述了在生物体内发现的一些重要的离子通道及其异常所导致的病症,演讲者本人也在糖尿病研究领域中取得了卓越的成果—她所研究的KATP离子通道揭示了Ⅰ型糖尿病的发病机理,并对疾病的治疗提供了依据。
剑桥大学公开课:生命 > 远古时代的生活(第4集)
http://v.163.com/movie/2012/10/1/5/M85KCL7B8_M85MDNT15.html
分集介绍:该讲座的主题是远古时代的生活,演讲者是任教于剑桥大学的迈克尔斯科特。他主要通过讲述不同时代的人对古希腊生活的不同看法和像古希腊这样的远古时代的生活对现代世界的价值,以引导人们找到对待远古时代生活的正确态度。随着古希腊艺术的风行,研究者对古希腊地貌、雕像、绘画和文字的痴迷,无疑是世界文艺中重要的一段。外国对古希腊文明的掠夺,后人为此所做的努力,以及古希腊适应现代欧洲道德而委曲求全的事实,这些均是古希腊历史中重要的一环。从特洛伊到奥林匹亚,古希腊又无疑是各国考古学的一个重要的研究对象。
剑桥大学公开课:生命> 矛盾中的生活(第5集)
http://v.163.com/movie/2012/10/O/F/M85KCL7B8_M85MDO1OF.html
分集介绍:该讲座的主题是矛盾中的生活,演讲者是剑桥大学贾奇商学院的马克戴隆德。他以战争,巴斯营地和剑桥划船社为例分析生活中可能存在的各种矛盾,并且指出了在矛盾的生活中应该怎样培养在各种矛盾间求取平衡的能力。战争是超现实的,而这超现实的特质是由矛盾引起的,朋友和敌人,内疚和杀戮,同情和漠然,竞争和合作,我们可以在任何领域以任何形式来发现矛盾。对待矛盾,不可暗箱操作,不可无视其存在,也不可纵容其错误发展,而应筑建心理安全感使其平衡达到最优。
剑桥大学公开课:生命 > 细胞的生死(第6集)
http://v.163.com/movie/2012/10/G/0/M85KCL7B8_M85MDO6G0.html
分集介绍:本视频是达尔文学院讲座系列的第六集,主题是细胞的生死。演讲者是Ron Laskey。他从以下几方面阐述了构成我们机体的基本单位细胞:活细胞简介,细胞分裂,细胞死亡,细胞更新,癌症简介以及神经退行性疾病。
剑桥大学公开课:生命 > 人造生命(第7集)
http://v.163.com/movie/2012/10/E/D/M85KCL7B8_M85MDOCED.html
分集介绍:人工生命是剑桥达尔文学院系列讲座的第七讲,主讲人Chris Bishop是爱丁堡大学计算机科学的教授,达尔文学院的理论物理学家,并且是剑桥微软实验室机器学习和感知小组组长。这一讲旨在揭开利用计算机模仿人类智能行为的奥妙,从而寻求计算机智能技术更长远的发展方向。
剑桥大学公开课:生命 > 来世(第8集)
http://v.163.com/movie/2012/10/P/3/M85KCL7B8_M85MDOFP3.html
分集介绍:本视频是来自以生命为主题的达尔文学院讲座的第八集:来世。演讲者是Clive Gamble。本视频从考古学的角度探讨了人类社会发展中对非生命的看法。来生是个体对未知旅程的想象,其中旅程的涉及个体的地方才是关键。来生是对升华的实质性回复,例如grog陶器碎片上的表现来生和亡灵的能力,而这种能力是由分散认知和应用通过FACE(破碎、聚集、消耗、绑定)过程的物质的手段来实现的。
图文整理︱artda.cn艺术档案网

